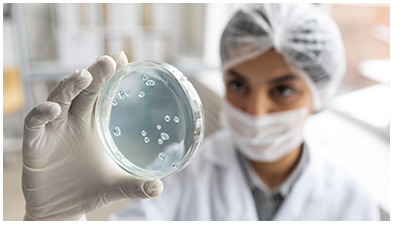

La Organización Mundial de la Salud (OMS) advirtió que la resistencia a los antibióticos está avanzando a un ritmo mayor que la innovación médica, lo que representa una amenaza creciente para la salud global. De acuerdo con el Informe Mundial sobre la Vigilancia de la Resistencia a los Antibióticos 2025, entre 2018 y 2023 se registró un incremento superior al 40% en la resistencia de combinaciones de patógenos y fármacos monitoreadas.
Según los datos, recopilados por más de 100 países a través del Sistema Mundial de Vigilancia de la Resistencia y el Uso de los Antimicrobianos (GLASS), una de cada seis bacterias confirmadas en laboratorio en 2023 fue resistente al tratamiento con antibióticos. Estas bacterias están asociadas a enfermedades comunes, muchas de ellas potencialmente graves o letales.
Por primera vez, el informe incluye datos de prevalencia de resistencia a 22 antibióticos usados para tratar infecciones urinarias, gastrointestinales, del torrente sanguíneo y gonorrea. El análisis se centró en ocho patógenos frecuentes, incluidos Escherichia coli, Klebsiella pneumoniae, Salmonella spp. y Acinetobacter spp.
"Más del 40% de las cepas de E. coli y más del 55% de las K. pneumoniae a nivel mundial son ahora resistentes a las cefalosporinas de tercera generación, tratamiento de primera elección para este tipo de infecciones", indica el informe.
En regiones como Asia Sudoriental, el Mediterráneo Oriental y África, el riesgo es mayor: una de cada tres infecciones en algunos casos presenta resistencia a múltiples fármacos. La situación se agrava al requerir el uso de antibióticos de última línea, que son más costosos y menos accesibles.
El director general de la OMS, Tedros Adhanom Ghebreyesus, advirtió que "la resistencia a los antimicrobianos está superando los avances de la medicina moderna, amenazando la salud de las familias en todo el mundo. Debemos usar los antibióticos con responsabilidad y garantizar el acceso universal a medicamentos adecuados, diagnósticos confiables y vacunas".
El director general de la OMS, Tedros Adhanom Ghebreyesus, advirtió que "la resistencia a los antimicrobianos está superando los avances de la medicina moderna, amenazando la salud de las familias en todo el mundo. Debemos usar los antibióticos con responsabilidad y garantizar el acceso universal a medicamentos adecuados, diagnósticos confiables y vacunas".
La OMS urge a ampliar estrategias de prevención, diagnóstico y tratamiento, además de fortalecer la innovación en antibióticos y herramientas moleculares rápidas. "Alcanzar esta meta requerirá acciones concertadas para fortalecer la calidad, cobertura geográfica e intercambio de datos sobre resistencia a los antimicrobianos", precisa el informe apuntado hacia que la resistencia a los antibióticos depende del material genético.
El Grupo de Coordinación Interorganismos sobre Resistencia a los Antimicrobianos clasifica este fenómeno como una de las diez principales amenazas para la humanidad. Según sus proyecciones, si no se toman medidas eficaces, para 2050 las muertes por infecciones resistentes podrían superar los 10 millones al año. "Nuestro futuro también depende de fortalecer los sistemas de prevención, diagnóstico y tratamiento de infecciones, así como de impulsar la innovación en antibióticos de nueva generación", concluyó Ghebreyesus. (NotiPress)



